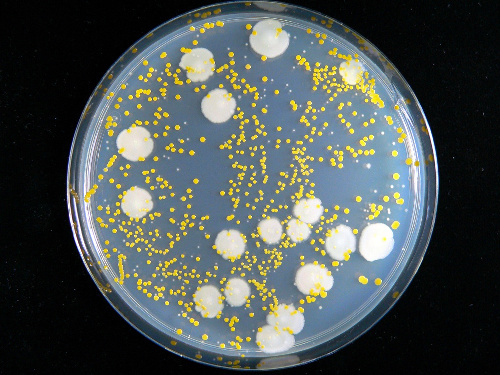

「ヨーグルトに整腸効果なし」研究結果で明らかに
おすすめ記事
1 名前:名無しさん@涙目です。(愛知県) 投稿日:2011/12/07(水) 14:10:56
ヨーグルトに効果なし? 双子の検討で腸内細菌に差なし
朝食やおやつ、夕食後のデザートなどとして、世界中で愛されているヨーグルト。含まれている乳酸菌の整腸作用を
期待して食べている人も多いのではないだろうか。ところが、実際にはそれほどの効果が期待できないかもしれない。
そんな研究結果が、米ワシントン大学のNathan McNulty氏らによって、米医学誌「Science Translational Medicine」
(2011; 3: 106ra106)に発表された。一卵性の双子を対象とした検討では、ヨーグルト摂取の有無で腸内細菌などの
変化に差が認められなかったという。
中略
具体的には、成人女性の一卵性の双子7組の一方に対し、5種類の乳酸菌を含む市販のヨーグルトを1日2回、7週間に
わたって食べるよう指示し、もう一方にはヨーグルトを食べないよう求めた。その間と前後4週間、定期的に採取した大便に
含まれる腸内細菌の種類や、どのような遺伝子が細菌の中で活性化されているのかを検討した結果、驚いたことに、
腸内細菌の種類やその比率、活性化している遺伝子の種類や量比、いずれもヨーグルト摂取の有無による違いは双子の
間に認められなかったという。
次にMcNulty氏らは、無菌マウスの腸内に、15種類のヒトの腸内細菌のみを人為的に定着させ、その活動に及ぼす
ヨーグルトの影響を調べた。すると、人間での検討結果同様、腸内細菌の種類やその比率にヨーグルト摂取の影響は
認められなかったが、活性化している遺伝子については、わずかながら差が認められた。糖を分解する酵素群の遺伝子が、
ヨーグルトの摂取により活性化したというのだ。
このわずかな差が、ヨーグルトが腸内細菌に与える効果のすべてだとしたら、これまでわれわれがヨーグルトに寄せていた期待は
あまりに大きかったということになる。ただし、人間での検討は、実験例が7人と少な過ぎる点、マウスの実験は人間の腸内細菌が
マウスの腸内で人間の腸内と同様の挙動を示すのか疑わしい点などを挙げ、結論するには時期尚早という意見もあるようだ。
いずれにしても、自分が効果を実感して食べているのなら、それはそれで良いのではないかという気もするのだが…。
http://kenko100.jp/news/2011/12/06/02
3 名前:名無しさん@涙目です。(岡山県) 投稿日:2011/12/07(水) 14:11:28
腸にやさしいビフィズス菌死亡
7 名前:名無しさん@涙目です。(東京都) 投稿日:2011/12/07(水) 14:12:16
そのヨーグルトは本物じゃなかったんだろ 本物食えよ
8 名前:名無しさん@涙目です。(東日本) 投稿日:2011/12/07(水) 14:12:23
ビオフェルミンは効くような気がする
9 名前:名無しさん@涙目です。(宮崎県) 投稿日:2011/12/07(水) 14:12:25
思い込みで意外に効果ある
11 名前:名無しさん@涙目です。(東日本) 投稿日:2011/12/07(水) 14:12:35
知ってた
12 名前:名無しさん@涙目です。(神奈川県) 投稿日:2011/12/07(水) 14:12:38
ヤクルト最強
13 名前:名無しさん@涙目です。(広島県) 投稿日:2011/12/07(水) 14:12:38
もやしもんに腹痛に効くって書いてなかったか
14 名前:名無しさん@涙目です。(大阪都) 投稿日:2011/12/07(水) 14:12:46
胃酸で死滅するんだよな
常識だろ
37 名前:名無しさん@涙目です。(三重県) 投稿日:2011/12/07(水) 14:14:06
>>14
おれそう思ってた
胃酸で死なないのピロリ菌くらいだろ
531 名前:名無しさん@涙目です。(アラバマ州) 投稿日:2011/12/07(水) 14:57:16
>>14
マジかよ・・・ヨーグルトカンチョーしか手は残されてないのか
15 名前:名無しさん@涙目です。(高知県) 投稿日:2011/12/07(水) 14:12:50
確かにヨーグルト食べて便秘解消したことなかった
18 名前:名無しさん@涙目です。(家) 投稿日:2011/12/07(水) 14:13:04
双子はリンクしてるから片方が食ったら両方に効果出るんだろ?
20 名前:名無しさん@涙目です。(徳島県) 投稿日:2011/12/07(水) 14:13:15
カルシウムを摂るためのもんだと思ってたわ
21 名前:名無しさん@涙目です。(新疆ウイグル自治区) 投稿日:2011/12/07(水) 14:13:16
結局は、体質と運動と食い物で9割決まるだろ、便通なんて
自分は超便秘だったけど、配達の仕事しだして一日中走りまわりメシもモリモリ食うようになって
から、快便になったな
22 名前:名無しさん@涙目です。(関東・甲信越) 投稿日:2011/12/07(水) 14:13:21
ビフィズス菌は酸素に触れた時点で死ぬ
32 名前:名無しさん@涙目です。(東京都) 投稿日:2011/12/07(水) 14:13:49
生きて腸に届かないのかよ
33 名前:名無しさん@涙目です。(関東地方) 投稿日:2011/12/07(水) 14:13:52
ヨーグレットも意味ないのか
ハイレモンは効果あるよな?
52 名前:名無しさん@涙目です。(関西・北陸) 投稿日:2011/12/07(水) 14:14:59
ヨーグルトが腹にいいと信じてる奴はコラーゲンで肌がぷるぷるとかそんなスイーツレベルだぞ
53 名前:名無しさん@涙目です。(茸) 投稿日:2011/12/07(水) 14:15:01
ブラシーボ効果無くすようなこと言ってんじゃねーよ
69 名前:名無しさん@涙目です。(東日本) 投稿日:2011/12/07(水) 14:15:28
ブルーベリー
ヨーグルト
野菜ジュース
三大インチキ
86 名前:名無しさん@涙目です。(岐阜県) 投稿日:2011/12/07(水) 14:16:09
いやー俺は実感できるけどな
87 名前:名無しさん@涙目です。(埼玉県) 投稿日:2011/12/07(水) 14:16:10
…信じてたのにっ!
91 名前:名無しさん@涙目です。(千葉県) 投稿日:2011/12/07(水) 14:16:14
コーヒー止めたら便秘になったから、毎朝ヨーグルト食ってみたけどダメだった
液体プルーンを追加投入してもダメだった、コーヒー飲んだら治った
93 名前:名無しさん@涙目です。(佐賀県) 投稿日:2011/12/07(水) 14:16:15
ピルクルは?ピルクルも効果ないの?
94 名前:名無しさん@涙目です。(dion軍) 投稿日:2011/12/07(水) 14:16:15
それでも食うよ
美味いから
109 名前:名無しさん@涙目です。(アラバマ州) 投稿日:2011/12/07(水) 14:17:04
他にいくらでもこういうのってありそうだよな
健康に良いと信じられてるものが全く効果ないってことが
126 名前:名無しさん@涙目です。(埼玉県) 投稿日:2011/12/07(水) 14:18:26
>>109
サカナのDHAとか
納豆のネバネバとか
ココアのポリフェノールとか
116 名前:名無しさん@涙目です。(九州地方) 投稿日:2011/12/07(水) 14:17:22
ケフィアは?ねぇケフィアはどうなの?
117 名前:名無しさん@涙目です。(大阪都) 投稿日:2011/12/07(水) 14:17:32
ヤクルトは大丈夫なんだろうな!?
120 名前:名無しさん@涙目です。(神奈川県) 投稿日:2011/12/07(水) 14:17:49
マジかよラムレーズン買ってくる
143 名前:名無しさん@涙目です。(鳥取県) 投稿日:2011/12/07(水) 14:20:23
>>123
マグネシウムを取り過ぎると下痢になるらしい
ココアにはマグネシウムが多く含まれてるせいではないかな
245 名前:名無しさん@涙目です。(関東・東海) 投稿日:2011/12/07(水) 14:27:32
>>170
腹壊してただけだろそれ
233 名前:名無しさん@涙目です。(東京都) 投稿日:2011/12/07(水) 14:26:35
インド行ったときラッシィ飲みまくってたのに
下痢が止まらなかった
納得だわ
234 名前:名無しさん@涙目です。(関西・東海) 投稿日:2011/12/07(水) 14:26:45
カスピ海ヨーグルトの粘りけは異常
224 名前:名無しさん@涙目です。(鹿児島県) 投稿日:2011/12/07(水) 14:25:51
じゃあ食った後に腹がボコボコ言ったり屁が出まくるのは何なの?
249 名前:名無しさん@涙目です。(東京都) 投稿日:2011/12/07(水) 14:28:03
>>224
日本人は乳糖を分解する酵素をもってないので腹を下してる
261 名前:名無しさん@涙目です。(東京都) 投稿日:2011/12/07(水) 14:28:50
>>249
へぇー
273 名前:名無しさん@涙目です。(SB-iPhone) 投稿日:2011/12/07(水) 14:30:05
>>249
屁が出まくるのは分解されてるって事だろ、知ったか()www
309 名前:名無しさん@涙目です。(dion軍) 投稿日:2011/12/07(水) 14:33:35
>>249
正解
ヨーグルト食べて便通が良くなるってのは実は錯覚で、日本人は乳糖を分解できないから
腹を下しているだけ
腸内でぼこぼこガスが動いている感じがしたらそれは乳糖が分解できずに発酵しているから
338 名前:名無しさん@涙目です。(静岡県) 投稿日:2011/12/07(水) 14:36:58
>>309
適度に腹が下って便秘にならないんなら、それもまた効果じゃねえの?
363 名前:名無しさん@涙目です。(dion軍) 投稿日:2011/12/07(水) 14:38:58
>>338
効果って言えば効果だろうけれども体に悪いよ
あとガスを我慢しているとそのガスは血管を通して体中に回る
肩や頭痛の原因にもなる
373 名前:名無しさん@涙目です。(千葉県) 投稿日:2011/12/07(水) 14:40:18
>>338
腹が下るってことは腸が栄養吸収するより先にまずこいつを出そうっていう反応だろ。
ダメージも残るし
255 名前:名無しさん@涙目です。(東京都) 投稿日:2011/12/07(水) 14:28:41
俺3年くらい前から下痢ばっかり出るんだけどどうすりゃいいんだ
飯食った後毎回腹痛くなって下痢が出る
食事中に水飲み過ぎるからそれが原因かな?
302 名前:名無しさん@涙目です。(新疆ウイグル自治区) 投稿日:2011/12/07(水) 14:33:07
>>255
ウンコが固まる食い物
柿・渋茶・梅酒。バリウム。
303 名前:名無しさん@涙目です。(東日本) 投稿日:2011/12/07(水) 14:33:09
>>255
食事中水飲みまくると消化明らかに弱くならね、あと水分吸収しきれなくて糞ビチビチ
汁ものは一杯が良いと思う
320 名前:名無しさん@涙目です。(関東地方) 投稿日:2011/12/07(水) 14:35:16
>>255
ちゃんとよく噛んでる?
365 名前:名無しさん@涙目です。(岡山県) 投稿日:2011/12/07(水) 14:39:02
>>255
マジレスすると、食器の漬け置き洗いを止めればおk
396 名前:名無しさん@涙目です。(東日本) 投稿日:2011/12/07(水) 14:42:32
>>365
なにそれ。すすげば一緒ではないか。
460 名前:名無しさん@涙目です。(静岡県) 投稿日:2011/12/07(水) 14:48:04
>>396
食器つけ置き、菌7万倍に 10時間で排水口並み :(;゙゚’ω゚’):
http://uni.2ch.net/test/read.cgi/news/1322116673/http://digital.asahi.com/articles/TKY201111230320.html?ref=twitter
食器つけ置き、菌7万倍に 10時間で排水口並み
2011年11月24日03時00分
 食後の食器を10時間水につけ置きすると、菌の数は約7万倍に増え、台所の排水口並みになるとの実験結果を、民
間の検査機関「衛生微生物研究センター」がまとめた。食器のつけ置きは菌が増えやすいと注意を呼びかけている。
食後の食器を10時間水につけ置きすると、菌の数は約7万倍に増え、台所の排水口並みになるとの実験結果を、民
間の検査機関「衛生微生物研究センター」がまとめた。食器のつけ置きは菌が増えやすいと注意を呼びかけている。
食後の食器を10時間水につけ置きすると、菌の数は約7万倍に増え、台所の排水口並みになるとの実験結果を、民
間の検査機関「衛生微生物研究センター」がまとめた。食器のつけ置きは菌が増えやすいと注意を呼びかけている。
食後の食器を10時間水につけ置きすると、菌の数は約7万倍に増え、台所の排水口並みになるとの実験結果を、民
間の検査機関「衛生微生物研究センター」がまとめた。食器のつけ置きは菌が増えやすいと注意を呼びかけている。
256 名前:名無しさん@涙目です。(神奈川県) 投稿日:2011/12/07(水) 14:28:45
まじかよビフィズス菌売ってくる




マジレスすると生きて届く必要もなければ
腸内細菌に直接影響を与える必要もない
働きは食物繊維に近いしな
でも!腸に届いて悪玉と戦うっていうから延々飲んでたのに!!!
ビヒヅス菌信じてた俺が馬鹿だったわ。でも体調子良い。ふしぎ!!!
ダノンビオはどうワビてくれんだ?
どーりで手が出るのはヤクルトって昔から体が知ってたんだな
そりゃ発酵乳のみヨーグルトとかあるからね
乳酸菌摂取したきゃサプリで摂ろうよ
お菓子ヨーグルトなんか食っても美味いだけだからさ
生きて腸に届く菌だよー、みたいなヨーグルトがあった気がしたけど、
あれだと結果が変わってくるのかな?
分解も発酵も化学反応としては似たようなもんなんだがなぁ….
乳酸菌生きてなくても、残骸さえあれば腸に住む菌が活性化するって聞いたことあるような….
たいした成果もあげてない研究チームの戯言を真に受けるなよ
乳酸菌が入っていない(死んでる乳酸菌=殺菌済み乳酸菌ではない、本当に入っていないただのデザート)ヨーグルトには何の整腸効果も見られないは正しいと思うよ
乳酸菌は死んでても生きてても腸内細菌を育てるのにいい働きをするよ
死んでてもいい菌にenterococcus faecalisって菌がいるんだよね
わからない場合は各自で調べ(ググっ)てくれ
花粉症に効くとかいうのはどうなの!!!><
でもタンパク質とカルシウムの補給源としてはいいだろう
マジレスしとくとだな
お菓子ヨーグルトは食うだけ無駄(美味いけどな)
ヨーグルトで乳酸菌摂取するよりちゃんと乳酸菌製剤摂って摂取しないとダメ
腹痛(特に胃・十二指腸が痛いやつ)にはLG21が効果あり
痛い時は2本一気飲みだと高確率で解決するから素晴らしい
※10
花粉症に効くやつもあるよ
でも効果は人によって違うから自分に合うの探せ
※11
お菓子ヨーグルトはそれ目的、でも糖分もはいるから牛乳飲んだ方が効果的
※6
生きて届くヨーグルト(乳酸菌)届く量が大問題
(業界的には1つでも生き残っていれば生きて届くと言ってもイイそうだ)
大多数がほぼ確実に生きて腸まで到達する菌株は宮入菌(ミヤリサン)と中山菌(有胞子性乳酸菌)な
生きて届いても合う合わんがあるから・・・・
効果あるよ。コーヒー飲みまくって下痢してるときに食うと
下痢がなおる。ソースは俺。
まあ なんつうか 完全に効く!っていうのが禁止されてるだけあって
効果ありますよ ってのは最もな詐欺行為な気がする
特に 白衣来た奴の写真のっけて、効果あるあるってアピールしてる商品とか